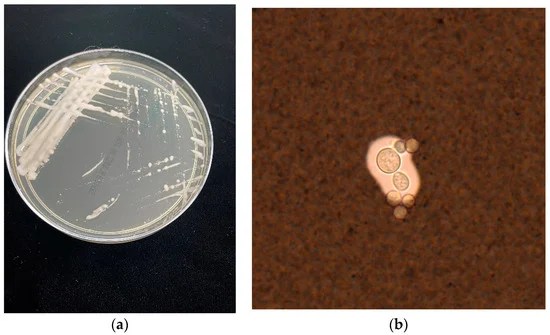

Etiyoloji ve Patofizyoloji
Kriptokokozis, Cryptococcus cinsine ait dimorfik mantar türlerinin neden olduğu bir enfeksiyondur. Kedilerde en sık görülen sistemik mikozdur. Hastalık her yaştan hayvanda görülebilmekle birlikte en sık 2 ila 7 yaş arasındaki kedilerde ortaya çıkar. Erkek kedilerin dişilere göre daha yatkın olduğu belirtilmiştir. Kedilerde kriptokokozis, bağışıklık sistemi ile yakından ilişkilidir; özellikle immünosüpresif durumlar (örneğin, FIV veya FeLV enfeksiyonları) hastalığın gelişme riskini artırabilir.
Kriptokok enfeksiyonlarının büyük çoğunluğu Cryptococcus neoformans ve Cryptococcus gattii türleri tarafından meydana gelmektedir. Bu mantarlar, dokularda dar tabanlı tomurcuklanma yöntemiyle çoğalarak enfeksiyon oluşturur.
Primer enfeksiyon genellikle burun boşluğu veya akciğerde lokalize olmakla birlikte, hastalığın ilerleyen aşamalarında lenf düğümleri, deri, göz ve merkezi sinir sistemi (MSS) gibi diğer organlara hematojen yolla yayılım gösterebilir. Özellikle MSS tutulumu gerçekleştiğinde, menenjit veya meningoensefalit gibi ciddi nörolojik komplikasyonlara yol açabilir.
Burun boşluğunda enfeksiyon gelişen hayvanlarda, patojenin lamina cribrosa yoluyla geçiş yaparak osteomiyelite neden olması ve beyin dokusuna yayılması da mümkündür.
Epidemiyoloji ve Risk Faktörleri
Moleküler çalışmalar, dünya genelindeki Cryptococcus suşlarının genetik ve fenotipik farklılıklarına dayanarak sekiz moleküler türe ayrıldığını ortaya koymuştur. Bu türler, farklı epidemiyolojik dağılım, patojenite düzeyleri, klinik belirti spektrumları ve antifungal ilaç duyarlılıkları ile karakterize edilmektedir.
Cryptococcus neoformans ve Cryptococcus gattii, kriptokokozun en yaygın etkenleri olup, çevresel rezervuarları açısından farklılık göstermektedir. C. neoformans, özellikle güvercin dışkısı ile kontamine alanlarda yaygın olarak bulunurken, C. gattii, çoğunlukla Avustralya’daki okaliptüs ağaçları ve Kuzey Amerika’nın batı kıyılarında bulunan belirli ağaç türlerinin çürüyen oyuk ve yarıklarından izole edilmiştir.
Epidemiyolojik veriler, kedilerde kriptokok enfeksiyonlarının, köpeklere kıyasla yaklaşık sekiz kat daha sık görüldüğünü ortaya koymuştur. Bu durumun, kedilerin çevresel maruziyet biçimleri ve potansiyel konak savunma mekanizmalarındaki farklılıklarla ilişkili olabileceği düşünülmektedir. Avustralya’da yapılan epidemiyolojik araştırmalar, Siyam, Birman ve Ragdoll gibi safkan kedilerin kriptokok enfeksiyonlarına karşı daha yatkın olabileceğini öne sürmüştür. Ancak, bu bulgu, Amerika Birleşik Devletleri’nde yapılan çalışmalarla doğrulanamamıştır, bu da coğrafi bölgelere bağlı olarak genetik yatkınlık veya çevresel faktörlerde farklılıklar olabileceğini düşündürmektedir.
Klinik Belirtiler
Kriptokok enfeksiyonları kedilerde genellikle kronik bir seyir izler ve iştahsızlık, halsizlik ile kilo kaybına neden olur. Üst solunum yollarında yerleşim gösteren enfeksiyonlar burun akıntısı, hapşırık gibi semptomlarla kendini belli eder ve sıklıkla mandibular lenfadenopati ile ilişkilidir. Ayrıca, burun deliklerinde polip benzeri kitle oluşumu gözlemlenebilir.
Deri veya mukozal tutulum söz konusu olduğunda, ülsere veya ülsersiz nodüller meydana gelebilir. Alt solunum yolu enfeksiyonları daha nadir görülmekle birlikte, şiddetli mediastinal lenfadenomegali veya plevral efüzyon gibi ciddi komplikasyonlara yol açabilir.
Merkezi sinir sistemi (MSS) tutulumu durumunda klinik belirtiler, lezyonun lokalizasyonuna bağlı olarak değişkenlik gösterir. MSS tutulumuna sahip kedilerin yaklaşık üçte birinde optik nörit ve korioretinit gibi oftalmik komplikasyonlar rapor edilmiştir. Ayrıca, periferik lenfadenopati, osteoartiküler enfeksiyonlara bağlı topallama ve nadiren abdominal organların (örneğin, böbrek, dalak, karaciğer) tutulumu da görülebilir.
Tanı
Kedilerde kriptokokozis tanısı, klinik bulguların yanı sıra sitolojik ve histolojik incelemelerle konur. Röntgen, akciğerlerdeki interstisyel veya alveoler desenleri, nodüler infiltratları ve plevral efüzyonu değerlendirmek için kullanılır. Bilgisayarlı tomografi (BT), özellikle kemik ve yumuşak doku lezyonlarını detaylı bir şekilde incelemek için faydalıdır, MRG ise merkezi sinir sistemi tutulumunu daha hassas şekilde tespit eder. Ayrıca, CALAS testi (lateks aglütinasyon testi), kriptokok antijenlerini tespit ederek tanıyı destekler ve tedavi yanıtını izlemek için kullanılır. PCR testi kullanılabilir.

Cryptococcus neoformans
Cryptococcus gattii
Halk Sağlığına Etkileri
Kriptokokoz, çevresel maruziyet sonucunda insanlarda gelişebilir. Bağışıklığı baskılanmış kişiler ve özellikle AIDS hastaları için ciddi bir enfeksiyon riski oluşturur. Hayvanlardan insanlara doğrudan bulaşma vakası bildirilmemiştir, ancak kontamine iğne batması,ısırık veya yara yoluyla organizma bulaşabilir. Cryptococcus, laboratuvar ortamında maya formunda büyür. Bu özellik, dimorfik mantarlar gibi küf formunda büyüyen türlere kıyasla laboratuvar çalışanları için daha düşük bir risk oluşturmasını sağlar.
Bu blog yazısı, Vet. Hek. Ayşe Zeynep ÇELİK tarafından doğrulanmıştır.
Kaynakça
1.Bruyette, D. S. (Ed.). (2020). Clinical small animal internal medicine. Hoboken, NJ: Wiley-Blackwell.
2.Tilley, L. P., & Smith, F. W. K. Jr. (2008). Veteriner hekimlikte 5 dakikada konsültasyon: Kedi ve köpek (T. Yeşildere & O. Deprem, Çev.). İstanbul: Nobel Tıp Kitabevleri.
3.VeterianKey. (t.y.). Cryptococcosis. VeterianKey. https://veteriankey.com/cryptococcosis-2/
4.AnimalWised. (t.y.). Cryptococcosis in cats: Cryptococcus infection. AnimalWised. https://www.animalwised.com/cryptococcosis-in-cats-cryptococcus-infection-3770.html
5.Ellis, D. H., & Pfeiffer, T. J. (1990). Natural habitat of Cryptococcus neoformans var. gattii. Journal of Clinical Microbiology, 28(7), 1642–1644.
6.Jacobs, G. J., Medleau, L., Calvert, C., & Brown, J. (1997). Cryptococcal infection in cats: Factors influencing treatment outcome, and results of sequential serum antigen titers in 35 cats. Journal of Veterinary Internal Medicine, 11(1), 1–4. https://doi.org/10.1111/j.1939-1676.1997.tb00064.x
7.Ettinger, S. J., & Feldman, E. C. (Eds.). (2005). Textbook of veterinary internal medicine: Diseases of the dog and the cat (6th ed., pp. 1918–1929). St. Louis, MO: Elsevier Saunders.
8.https://tr.m.wikipedia.org/wiki/Cryptococcus_neoformans görsel kullanılmıştır.
9.https://www.mdpi.com/2309-608X/9/1/41 görsel kullanılmıştır.





